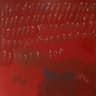
rosa rugosa

+1
Images
Blumengarten
The German music duo Blumengarten consists of singer Rayan Djima and music
producer Samuel "Sammy" Eickmann. Both hail from Velbert, North
Rhine-Westphalia, and founded the band in 2021. Their musical style combines
elements of indie, pop, house and hip-hop. Their first EP Sag deinen Freunden,
dass du sie liebst is released in 2022 and includes three tracks. The song
"Paris Syndrom" receives special attention through a new edition with Paula
Hartmann as "Dach Session". The second EP Versprechen, alles wird gut! follows
in early 2023, which is honored with the Polyton award in ...
DaheimBlumengarten
Ich liebe dich für immer
3:09
rosa rugosaLucry & Suena, 01099, Gustav, Zachi and Blumengarten
Rosa Rugosa
2:17
Ich lieb dich für immer (Ich lieb dich fuer immer)Blumengarten
Ich liebe dich für immer
2:44
SupernovaBlumengarten
Ich liebe dich für immer
3:27
nie wieder normalCRO and Blumengarten
Spacejam
3:18
gloriaBlumengarten
Gloria
2:33